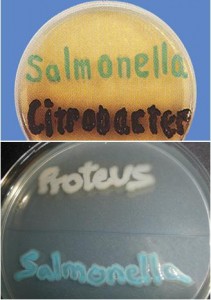
Chromosalm

Salmonella cromogénico ABC ISO 6579 diferenciación enzimática Salmonella: colonias verdiazules,del resto de Enterobacterias: negras/incoloras
MICROKIT® CROMOSALM AGAR es un medio cromogénico para Salmonella (Investigación de la Beta-Galactosidasa )(UNE 34-554:1983, UNE 34-818:1985, EN-12824:1997, UNE-EN ISO 6579:2003)
Nuestro medio MICROKIT® CROMOSALMChromosalm agar es un medio cromogénico para aislar colonias del género Salmonella de forma diferencial y específica. Totalmente diferente a los medios cromogénicos de Salmonella de otras marcas, que tienen cromógenos color rojizo mucho menos específicos.
Salmonella puede diferenciarse de otras Enterobacterias gracias a su mecanismo para producir alfa-galactosidasa en ausencia de beta-galactosidasa. MICROKIT® CROMOSALM incorpora dos sustratos cromogénicos, CHE-Gal y X-alfa-gal, que permiten visualizar esta actividad en la misma placa. Efectivamente, CHE-Gal es metabolizado por la beta-galactosidasa, produciendo colonias negras en presencia de hierro, como ocurre en la mayoría de Enterobacterias. X-alfa-gal es hidrolizado por Salmonella produciendo colonias verde-azuladas, claramente distinguibles de las de otras Enterobacterias, negras y de las de otros microorganismos, incoloras. Las reacciones cromogénicas están muy concentradas en las colonias, dejando al medio de su color natural, crema. El resto del medio está basado en la fórmula DCA de Hynes, utilizando desoxicolato sódico y citrato sódico como inhibidores de la flora acompañante. Gracias a todo ello, MICROKIT® CROMOSALM detecta las cepas enterotoxigénicas de Salmonella (S.enteritidis, S.typhimurium, S.paratyphi…) y también detecta S.typhi, en todo tipo de muestras alimentarias, clínicas, agua…
Muchos medios para aislamiento de Salmonella (incluidos muchos otros modernos medios cromogénicos con Magenta-Gal) son poco selectivos y/o diferenciales, provocando un inmenso gasto en confirmaciones de colonias sospechosas que resultan ser negativas (Proteus, Citrobacter…). Con una asombrosa especificidad (99,7%), MICROKIT® CROMOSALM reduce drásticamente la necesidad de confirmar falsos positivos, ahorrando trabajo y grandes costes en medios adicionales, galerías bioquímicas y pruebas inmunológicas: ¡Requiere un 95% menos confirmaciones de colonias que los medios tradicionales!.
Pero además, con frecuencia, en los medios habituales para Salmonella, los crecimientos abundantes de flora acompañante enmascaran a Salmonella cuando está presente en bajas proporciones. La incidencia de falsos negativos en MICROKIT® CROMOSALM es también ínfima, ya que la sensibilidad es del 90,5%, obteniéndose un 14% más positivos reales que en los demás medios.
|
Colonias verdes: Salmonella. Colonias negras: otras Enterobacterias, incluida Citrobacter. Colonias incoloras: Proteus |
Si desea más información sobre nuestro medio MICROKIT® CROMOSALM, no dude en ponerse en contacto con nosotros a través de nuestro correo electrónico microkit@microkit.es o por teléfono en el nº 91-897 46 16. Para pedir este medio contacte con pedidos@microkit.es
https://www.microkit.es/pdf/cromosalm.pdf
Prepárese para más de una sorpresa informativa cuando vea nuestro video sobre los medios Cromogénicos: https://www.youtube.com/watch?v=-JVPVWxY8ZE&t=271s